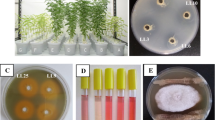

Abstract
Pea (Pisum sativum) is one of the most popular legume crops used in agriculture. Because of the high demand and relatively reasonable price, Lithuania has increased the cultivation of this crop and invested in the research of new effective breeding lines in the last years. Rhizobial inoculants contribute to increasing yield in legumes through N2 fixation. Therefore, the objective of this work was to identify rhizobial strains able to increase the activity of two pea breeding lines (‘DS 3637–2’ and ‘DS 3795–3’) known for high productivity, resistance to biotic and abiotic stresses, and competitiveness in respect to weeds. Six rhizobial strains isolated from pea plants were identified as members of the Rhizobium leguminosarum group and phenotypically characterized in depth by Phenotype Microarray (PM). Phenotypic differences observed were linked to their phylogeny. Then, strains were tested for their ability to stimulate the growth of the breeding lines ‘DS 3637–2’ and ‘DS 3795–3’. Reference strain Rhizobium anhuiense Z1 and Rhizobium leguminosarum sv. viciae 14ZE showed the best symbiotic performances with breeding lines ‘DS 3637–2’ and ‘DS 3795–3’, respectively. Based on the obtained results, R. leguminosarum sv. viciae strain 14ZE appears to be a new effective inoculant of peas.
Similar content being viewed by others
Avoid common mistakes on your manuscript.
1 Introduction
Among legume crops used in agriculture, field pea (Pisum sativum) is one of the most popular grain legumes, accounting for 16% of world pulse production (Drew et al. 2012). Lithuania, similarly to the other Baltic States, is a country with a longstanding experience in pea cultivation owing to suitable climate and terrain for producing high yielding pulse legumes. Originally, pea crops occupied only about 0.85% of the total arable land (14.9 thousand ha) (Seibutis and Deveikyté 2006). However, the area of pea crops production progressively increased in the last years, covering from 79.4 (2015) to 106.2 (2018) thousand ha of Lithuanian lands (FAOSTAT 2021), and Lithuania became a significant producer of dry beans and dry peas among European Union countries (FAOSTAT 2021).
Rhizobia are a paraphyletic group of well-known bacteria involved in beneficial symbiosis with leguminous plants in a host-specific way (Gage 2004), contributing with a remarkable proportion to the biological nitrogen fixation (BNF) (Udvardi and Poole 2013). In recent years, the exploitation and the improvement of BNF of field pea is a key element for eco-sustainable agriculture (Holt-Giménez and Altieri 2013; Bellabarba et al. 2019; Pastor-Bueis et al. 2019). It was estimated that more than half of the biologically fixed nitrogen worldwide is yielded by rhizobium-legume symbioses (Smil 2004). Moreover, concerning pea crops, BNF can provide over 80% of the nitrogen content in pea plants, while an average of 25–35 kg/ha of nitrogen is introduced in the soil, depending on the tillage system (Ruisi et al. 2012). Consequently, the employment of rhizobial strains as inoculants able to replace commonly used N-fertilizers has become of primary importance and a goal to be achieved for economic and environmental implications (Baset Mia and Shamsuddin 2010; Bhardwaj et al. 2014). Therefore, the isolation and phenotypic screening of rhizobial strains to select as bioinoculants is a crucial strategy. Such screening is also important because the effective symbiosis can be affected by many other factors, like host-specificity and the ability of selected stain to compete with the local rhizobia (Abi-Ghanem et al. 2013; Bourion et al. 2018). The benefits provided for the same legume species by the different rhizobial strains at a given location can vary up to 10-fold (Denison and Kiers 2004).
The Rhizobium genus includes more than 90 species; within this genus, the rhizobia can nodulate different leguminous host plants. The most studied species is R. leguminosarum, which could be further classified in different symbiovars depending on the host plant it nodulates: R. leguminosarum sv. viciae infects plants of tribe Viciaea, like pea (Pisum sativum L.) and vetches (Vicia L.), while clovers (i.e., Trifolium L.) are nodulated by R. leguminosarum sv. trifolii and common beans (Phaseolus vulgaris L) are nodulated by the symbiovar phaesolii (Rogel et al. 2011). A tribe could then be nodulated by many different Rhizobium species, i.e., plants belonging to the Viciaea tribe may establish symbiotic relations with R. pisi, R. fabae, R. laguerreae, R. lentis, R. bangladeshense, R. binae, R. anhuiense, and R. indicum (Rahi et al. 2020). Symbiotic interactions between pea and rhizobia are highly selective, i.e., the Afghan Pisum sativum cv. Afghanistan is nodulated by specific R. leguminosarum sv. viciae strains present in Afghan and Turkish soils (Mutch and Young 2004).
In the rhizobia-legume symbiosis, each nodule originates from a separate infection (Kumar et al. 2015). Flavonoids and betaines, released by the root of host-plant attract rhizobia present in the rhizosphere and activate the transcription of nodulation (nod) genes, which are located on a large symbiosis plasmid or symbiosis islands. The nod genes are responsible for the biosynthesis of nodulation signals (Nod factors), which initiate many of the developmental changes in the roots (Gage 2004). Host specificity depends on nod factors, and the polymorphisms of nodC gene are commonly used as phylogenetic markers for Rhizobium symbiovar identification (Rogel et al. 2011; Peix et al. 2015). Most symbiovars are currently defined based on the range of legumes they can nodulate, and this is mainly based on the nodC gene analysis, whose phylogenies make possible the correct differentiation of these categories within species of all rhizobial genera (Peix et al. 2015).
Strains of the same Rhizobium species recovered from the same field may be genetically different; R. leguminosarum sv. trifolii strains isolated from nodules of clover plants growing in each other’s vicinity showed considerable genetic and metabolic variability (Wielbo et al. 2010; Abi-Ghanem et al. 2013).
Metabolic properties may be an important trait in determining nodulation efficiency of rhizobia. Indeed, the ability to metabolize a broad range of carbon and energy sources (especially amino acids and their derivatives) may increase the chance for nodulation of a given strain (Wielbo et al. 2007, 2010). Phenotype microarray is not a time-consuming procedure to examine the metabolic profiles of bacteria; therefore, it could be used to screen rhizobial strains in terms of metabolic versatility (Biondi et al. 2009; Fagorzi et al. 2020).
In the frame to increase the productivity of two Pisum sativum emerging breeding lines in Lithuania because of their high productivity, resistance to biotic and abiotic stresses, and competitiveness in respect to weeds (unpublished data), rhizobial strains able to establish an efficient symbiosis were selected and characterized to develop efficient legume-growing systems to be employed as eco-sustainable agronomic practices.
2 Materials and methods
2.1 Isolation of rhizobial strains
Rhizobial strains were isolated from nodules of the four most popular pea cultivars (‘Ieva DS’, ‘Casablanca’, ‘Respect’, and ‘Lump’) and five breeding lines (‘DS 3637-2’, ‘DS 3486-12’, ‘DS 3751-1’, ‘DS3783-3’, and ‘DS 3789-1’) at the flowering stage. Plants were grown for two months (until reaching the flowering stage) in the greenhouse, where the length of the illumination was set up to 16 h, the temperature was 20 ± 2°C, and plants were watered according to the need. Soil for plant growth was collected a few days before experiment setup at 15–20 cm depths from an uninoculated experimental field at the LAMMC ZI Institute (55° 23’ 50” N, 23° 51’ 40” E). According to the world reference base for soil resources (WRB), the loamy textured soil was classified as an Endocalcic-Epihypogleyic Cambisol (IUSS Working Group WRB 2015). Soil chemical properties of samples were a pH of 6.7and had labile phosphorus (P2O5) 219 mg/kg, labile potassium (K2O) 230 mg/kg, total nitrogen (N) 5.87 mg/kg, and organic carbon (Corg) 1.53% (Agrochemical Research Laboratory, Kaunas Lithuania).
Single healthy-looking pink nodules (large than 2 mm) were selected from a single plant per cultivar/breeding line and excised. Nodules were surfaced sterilized with 95% ethanol for 10 s and sodium hypochlorite solution containing 3.0% of active chlorine for 3 min, washed five times in sterile deionized water, crushed, and re-suspended in 50 μL of sterile deionized water. Crushed nodule suspensions were serial diluted (1/10 in saline solution) and plated on yeast-mannitol agar (YMA) [0.5 g/L K2HPO4, 0.2 g/L MgSO4, 0.1 g/L NaCl, 1.0 g/L CaCO3, mannitol 10.0 g/L, yeast extract 1.0 g/L, agar 20 g/L (Vincent 1970)] and incubated at 28°C for 48 h. Strains were purified streaking a single colony on new YMA plates at least five times. Pure strain cultures were stored in 20% (v/v) glycerol at −80°C.
2.2 16S rRNA, recA, atpD, and nodC PCR amplification and sequence data analysis
For each strain, a single colony was picked from an YMA plate and re-suspended in 50 μL deionized sterile water. The bacterial suspension was maintained at 100°C for 10 min for cellular lysis, cooled in ice for 2 min, and subsequently centrifuged at 10000 × g for 5 min. Amplification reactions were performed in a 20 μL volume, containing 2 μL of the supernatant as a template. The 16S rRNA was amplified with bacterial universal primer pair 27F 5′-(AGAGTTTGATCMTGGCTCAG)-3 and 1387R 5′-(GGGCGGWGTGTACAAGGC)-3′ (Lane 1991). The composition of the reaction mixture was the following: 1X reaction Buffer (10 mM Tris pH 8.3, 50 mM KCl, 1.5 mM MgCl2), 200 μM of each dNTP, 0.1 mg/mL of bovine serum albumin, 0.1 μM of each primer, and 0.05 U of Taq DNA polymerase (Thermo Scientific, Massachusetts, U.S.A.). PCR conditions consisted of an initial denaturation at 94°C for 5 min, 30 cycles at 95°C for 30 s, 55°C for 30 s, and 72°C for 90 s, and a final extension at 72°C for 5 min.
The nodC gene was amplified with primers NodCF 5’-(AYGTHGTYGAYGACGGTTC)-3’ and NodCI 5’-(CGYGACAGCCANTCKCTATTG)-3’ (Laguerre et al. 2001). The atpD gene was amplified with primers AtpD273f 5’-(SCTGGGSCGYATCMTGAACGY)-3’ and AtpD771r 5’-(GCCGACACTTCCGAACCNGCCTG)-3’ (Gaunt et al. 2001). The recA gene was amplified with primers RecA6F 5’-(CGKCTSGTAGAGGAYAAATCGGTGGA)-3’ and RecA555r 5’-(CGRATCTGGTTGATGAAGATCACCAT)-3’ (Gaunt et al. 2001). Amplification was performed as described above with the only exception of primer concentrations (0.4 μM of each primer). PCR conditions consisted of an initial denaturation at 94°C for 5 min, 30 cycles at 95°C for 30 s, 55°C for 30 s, and 72°C for 60 s, and a final extension at 72°C for 5 min.
The PCR amplicons were purified with the Genejet PCR purification kit (Thermo Scientific) and subsequently sequenced by Applied Biosystems 3730XL DNA Analyzer using the same primer set used in PCR amplification. All the sequences were analyzed and edited with BioEdit software (Hall 1999). Phylogenetic analyses of 16S rRNA, atpD, and recA genes included sequences of Rhizobium type strains. The sequences of the nodC gene were used as queries to identify related genes using the NCBI BLASTn tool (Altschul et al. 1990) and the non-redundant nucleotide database without a limit to sequences from type material. Phylogenetic analyses were performed using the maximum-likelihood method, selecting the best model for each phylogenetic analysis (Saitou and Nei 1987; Tamura et al. 2004) in the MEGA software (ver. X) (Kumar et al. 2018; Stecher et al. 2020). All ambiguous positions were removed for each sequence (complete deletion option). The 16S rRNA gene, nodC, atpD, and recA gene amplicon sequence data are available at GenBank database with the accession numbers MT775515-MT775524 for the 16S rRNA sequences, MT786692-MT786701 for the nodC sequences, MW216573-MW216582 for the atpD sequences, and MW216563-MW216571 for the recA sequences.
2.3 RAPD analysis
Random Amplification of Polymorphic DNA (RAPD) was performed for all the bacterial strains using primers P7 5’-(CCAAGCTGCC)-3’ (Kumar et al. 2009) and AP5 5’-(TCCCGCTGCG)-3’ (Caccamo et al. 1999). Amplification reactions were performed as described above with the only exception that only one primer was used at a concentration of 1 μM. PCR conditions were the following: 95°C for 5 min, 40 cycles at 95°C for 1 min, 35°C for 1 min, and 72°C for 1 min and a final extension at 72°C for 7 min. Amplification products were separated by gel electrophoresis on 2% agarose gel and visualized under UV illumination after staining with ethidium bromide.
The sizes of RAPD fragments were estimated by comparison with the marker (GeneRuler 1kb DNA ladder, Thermo Scientific. RAPD fingerprints obtained with both primer AP5 and P7 were recorded in binary form, i.e., 1 = presence of a band and 0 = absence of a band. The RAPD matrices obtained with both primers (P7 and AP7) were joined for subsequent cluster analysis. Cluster analyses were performed using the Jaccard similarity coefficient (J) (Sneath and Sokal 1962) and the algorithm UPGMA (unweighted pair-group method, with arithmetic mean) using PAST v3.25 software (Hammer et al. 2001).
2.4 Plant tests
Two Pisum sativum breeding lines ‘DS 3637-2’ and ‘DS 3795-3’ were used as host plants. Seeds were surface-sterilized for 1 min in 70% ethanol, rinsed with sterile deionized water, immersed for 5 min in sodium hypochlorite solution containing 5% active chlorine, and washed five times in sterile deionized water. Surface sterilized seeds were allowed to germinate on the cover of sterile plastic Petri dishes over a layer of sterile wet Whatman paper at room temperature. After 4 days in the dark seedlings were transferred to plastic pots filled with a sterilized mixture of sand and vermiculite in a 1:3 ratio and supplied with 100 mL of Nitrogen-free solution [1mM CaCl2·2H20, 0.1 mM KCl, 0.8 mM MgSO4 7H2O, 10 μM Fe EDTA, 35 μM H3BO3, 9 μM MnCl2·4H2O, 0.8 μM·ZnCl2, 0.5 μM Na2MoO·2H2O, 0.3 μM CuSO4·5H2O, 3.68 mM KH2PO4, and 4 mM Na2HPO4, pH = 6.5] (Ramachandran et al. 2011).
The Rhizobium strains were grown at 30°C in liquid TY (Beringer 1974) to the late exponential phase (OD600 = 0.6–0.8), pelleted, and re-suspended to an OD600 of 0.05 in a 0.8% NaCl solution. 7-day-old seedlings were inoculated with 5 × 107 rhizobial cells. Five replicates for each Rhizobium strain per breeding line were tested. Uninoculated plants were used as a negative control. Plants were grown in a greenhouse under artificial light (luminous flux 3000 lmn, color temperature 4000 K) with a 16-h photoperiod at 22 ± 2°C. Every 6–8 days plants were watered with sterilized water. Twenty-eight days after inoculation, chlorophyll fluorescence measurements were performed. Intact flag leaves of pea plants were adapted to darkness for 30 min using light-withholding clips. Fluorescence was measured with a portable non-modulated fluorimeter Handy PEA (Plant Efficiency Analyser, Hansatech Instruments, Kings Lynn, UK). The maximum quantum yield of primary photochemistry in the dark-adapted state was expressed for each strain per cultivar/breeding line according to the formula: φPo = [Fm-Fo]/Fm = Fv/Fm] (Bussotti et al. 2011).
The harvested plants were furthermore evaluated for shoot length, number of nodes, number of nodules, and dry weight. Statistical analyses were performed using Rstudio (R Core Team 2011). All data were evaluated for normality with the Shapiro-Wilk test. One-way ANOVA and Tukey post hoc tests were performed for the analysis of shoot length, wet weight, and dry weight by using agricolae package. For φPo, the number of nodules and number of nodes Nonparametric Kruskal-Wallis and post hoc Dunn tests were performed using the FSA and rcompanion packages. A principal component analysis was performed by using PAST v3.25 software (Hammer et al. 2001).
2.5 Phenotype microarray
Bacterial strains were characterized using PM1-2 for carbon sources, PM3 for nitrogen sources, PM9 for osmolarity, and PM10 for pH. The complete list of assayed compounds can be obtained from http://www.biolog.com/pdf/PM1-PM10.pdf.
Bacterial strains were grown on TY agar medium (Beringer 1974) and incubated at 27°C for 48 h; then, colonies were picked up with a sterile cotton swab and suspended in 15 mL of NaCl 0.8% solution. Cell density was adjusted to OD600 = 0.1. Media for PM1 and PM2 and PM3 were obtained using UMS medium [20 mM 4-morpholine ethanesulfonic acid, 0.5 mM K2HPO4, 8.5 mM NaCl, 10 mM NH4Cl, 10 mM glucose, 2 mM MgSO4·7H2O, 0.51 mM CaCl2·2H2O, 0.4 μM biotin, 4.2 μM Ca-pantothenate, 3.0 μM thiamine, 1 μM Na2EDTA, 40 μM FeSO4·7H2O, 0.6 μM ZnSO4·7H2O, 0.08 μM CuSO4·5H2O, 4.2 μM CoCl2·6H2O, 0.9 μM MnSO4·4H2O, 4 μM H3BO3, 0.8 μM NaMoO4·2H2O, pH 6.5] (Pini et al. 2017) with some modifications. The UMSC was obtained from UMS, without the carbon source (glucose) and used for PM1 and PM2, and the UMSN was obtained from UMS without the nitrogen source (ammonium chloride) and used for PM3. The inoculation fluids for PM1 and PM2 were obtained diluting the cellular suspension (OD600 = 0.1) 10 times in UMSC and added with 1X Dye Mix A (Biolog, Hayward, California, U.S.A.). The inoculation fluid for PM3 was prepared by diluting the cellular suspension (OD600 = 0.1) 10 times in UMSN added with 1X Dye Mix A (Biolog). The inoculation fluids for PM9 and PM10 were prepared by diluting the cellular suspension (OD600 = 0.1) 10 times in TY added to 1X Dye Mix A (Biolog). Finally, the inoculation fluids were dispensed into PM plates (100 μL per well). The PM plates were sealed with Breathe-Easy® gas-permeable membrane (Sigma-Aldrich, St. Louis, Missouri, U.S.A.) to avoid fluid drying and incubated statically at 27°C in an OmniLog Reader (Biolog) for 96 hours. Readings were recorded for 96 hours, and data were analyzed using OmniLog-PM software (Biolog), which generated a time course curve for tetrazolium color formation. Each experiment was performed in duplicate. The data from the OmniLog-PM software (release OM_PM_109M) were filtered using the area of the kinetic curves as a parameter and then transferred to Excel spreadsheets (Microsoft Corporation). For each carbon and nitrogen source, the average area was calculated (n = 2). Carbon and nitrogen sources were considered to be used by the strains when the average area was 50% higher than the average area detected in the negative control (A01 well). The TMEV software (Saeed et al. 2003) was used to produce heatmaps of the carbon and nitrogen sources utilization, principal-component analysis (PCA) was performed using the PAST v3.25 software (Hammer et al. 2001) to establish the relationships between the phenotype profiles of the strains.
3 Results and discussion
3.1 Isolation and identification of rhizobial strains
Nine rhizobial strains (2ZE, 3ZE, 4ZE, 7ZE, 9ZE, 11ZE, 13ZE, 14ZE, and 15ZE) were isolated from the nodules of different pea cultivars/breeding lines grown in laboratory conditions. The strain Z1 was added because it is traditionally used in the Institute of Agriculture, Lithuanian Research Centre for Agriculture and Forestry (LAMMC ZI) for the inoculation of pea plants in field experiments. Moreover, the Z1 strains lack genotypic and phenotypic characterization.
Based on phylogenetic analysis by 16S rRNA genes, all strains (including strain Z1) were attributed to the R. leguminosarum group (Supplementary Fig. S1). The R. leguminosarum group includes R. leguminosarum sv. viciae USDA 2370T, R. laguerreae FB206T, R. sophorae CCBAU 03386T, R. anhuiense CCBAU 23252T, R. acidisoli FH13T, R. ruizarguesonis UMP1133T, and R. hidalgonense FH14T, which show 99.9% 16S rRNA gene sequence similarity (Rahi et al. 2020).
The 16S rRNA gene sequencing did not allow the differentiation of strains; therefore, we proceeded typing the strains by RAPD and sequencing the atpD and recA genes, which are commonly used to differentiate species within the R. leguminosarum group (Gaunt et al. 2001). All strains showed different RAPD profiles, except for strains 13ZE and 7ZE (Supplementary Fig. S2). The clustering of RAPD profiles divided the strains into two main groups. The first group contained the strains 3ZE, 7ZE, 11ZE, 13ZE, and 15ZE, while the second group included the strains 2ZE, 4ZE, 9ZE, and 14ZE. The reference strain Z1 was not associated with any other cluster in the dendrogram. Phylogenetic analysis on the concatenated sequences of atpD (nucleotide sequence from position 352 to 747) and recA (nucleotide sequence from position 160 to 504) confirmed RAPD analysis. The group was formed by the 2ZE, 4ZE, 9ZE, and 14ZE clusters with R. leguminosarum sv. viciae USDA 2370 (genospecies E), while the group formed by 3ZE, 7ZE, 11ZE, 13ZE, and 15ZE was related to R. leguminosarum sv. viciae 3841 (genospecies B) (Fig. 1). Indeed, within the R. leguminosarum species there have been identified several different genospecies, though initially only 5 genospecies were characterized (Kumar et al. 2015), recently extensive genomic analysis has subdivided R. leguminosarum into 18 different genospecies, which include R. laguerreae, R. sophorae, R. ruizarguesonis and R. indicum (Young et al. 2021). Strain Z1, which was the outgroup in the RAPD profile, clustered with the sister clade R. anhuiense (99.87% sequence identity) (Fig. 1).
Phylogenetic tree based on the concatenated alignment of atpD and recA gene sequences inferred using the maximum likelihood and general time reversible model. The percentage of trees in which the associated taxa clustered together is shown next to the branches. Initial tree(s) for the heuristic search were obtained automatically by applying Neighbor-Join and BioNJ algorithms to a matrix of pairwise distances estimated using the general time reversible model, and then selecting the topology with superior log likelihood value. Letters in circles indicate the different R. leguminosarum genospecies. The tree is drawn to scale, with branch lengths measured in the number of substitutions per site. There were 738 positions in the final dataset
The polymorphisms of nodC genes are commonly used as phylogenetic markers of Rhizobium symbiovars (Peix et al. 2015). The phylogenetic tree based on nodC gene sequences showed that all the strains, including the reference strains Z1, belong to the symbiovar viciae (Fig. 2). Strains 3ZE, 9ZE, 11ZE, 13ZE, and 15ZE showed a similar nodC sequence and cluster with the nodC sequence of the type strain Rhizobium leguminosarum sv. viciae USDA2370T (from 97.99% to 99.37% of sequence identity). The other sequences are scattered in the phylogenetic tree. The nodC sequence of 14ZE is identical (100%) to the R. pisi DSM 30132 nodC sequence. Strains Z1 and 2ZE showed 99.5% of nodC sequence identity. The finding that all the strains belong to the symbiovar viciae is per the previous statement that Fabeae legumes, such as peas and fava beans, form symbiotic nodules with bacteria belonging to different Rhizobium species, with R. leguminosarum sv. viciae being the most common symbiont for several Pisum sativum varieties (Andrews and Andrews 2017). Other Rhizobium species able to nodulate plants of the Fabeae tribe (also referred to as the Vicieae) are R. laguerreae, R. sophorae, R. anhuiense, R. ruizarguesonis, R. pisi, R. fabeae, and R. multihospitium, which show high sequence similarity of their nodC gene suggesting past events of horizontal gene transfer between these species (Andrews and Andrews 2017; Zhang et al. 2019; Jorrin et al. 2020).
Phylogenetic tree based on the alignment of nodC gene sequences inferred using the maximum likelihood and general time reversible model. The percentage of trees in which the associated taxa clustered together is shown next to the branches. Initial tree(s) for the heuristic search were obtained automatically by applying Neighbor-Join and BioNJ algorithms to a matrix of pairwise distances estimated using the General time reversible model, and then selecting the topology with superior log likelihood value. The tree is drawn to scale, with branch lengths measured in the number of substitutions per site. There were 444 positions in the final dataset
Based on molecular analyses, six strains were selected for further characterization. Strain Z1 was selected because was the only strain clustering with R. anhuiense, and it is the strain commonly used as an inoculant. Strains 2ZE, 9ZE, and 14ZE were chosen as representatives of R. leguminosarum genospecies E, and strains 13ZE and 15ZE were representative of R. leguminosarum genospecies B.
3.2 Phenotype microarray analysis: Utilization of carbon and nitrogen sources, sensitivity to pH and osmolotyes
The ability of rhizobia to establish an effective symbiosis with the target plants depends not only on the plant-bacterium interactions but also on several environmental factors, which affect nodulation and nitrogen fixation (Zhang and Smith 2002). Effective rhizobial inoculant must survive in the soil adapting to different chemical-physical proprieties (i.e., pH and salinity), and it must win the competition with native rhizobia and other rhizosphere microorganisms. Nutrient contents in the rhizosphere are influenced by plant roots, which exude large quantities of sugars, organic acids, and amino acids (Gaworzewska and Carlile 1982; Pini et al. 2017), thus affecting the growth of rhizosphere-colonizing bacteria (Jaeger et al. 1999).
Adaptation to different environmental/stress conditions is of fundamental importance to increase the chances for nodulation. Therefore, phenotype microarrays were used to screen the ability of the Rhizobium strains to use different nutrients, tolerance to osmotic stressors, and pH conditions (Fig. 3 and S3).
Phenotypic features of Rhizobium isolates. Six Rhizobium isolates (2ZE, 9ZE, 13ZE, 14ZE, 15ZE, and Z1) were screened for their capabilities to use a. carbon (PM1–2) and b. nitrogen (PM3) sources and c. for their pH sensitivity [PM10 (wells A1–A12)]. Data are expressed in Arbitrary OmniLog Units (AOU) and represent the area under the kinetic curves after 96 h of incubation in the OmniLog instrument at 27 °C. The AOU values are reported in grayscale. For carbon and nitrogen sources (panel a and b), the scale ranges from white indicating the average AOU detected in the negative control [well A01] to black indicating the maximum AOU value. In panel c, the grayscale ranges from 10,000 AOU (white) to 100,000 AOU (black). For each condition, the reported AOU is the average obtained from two replicates. d. Principal component analysis of PM data (PM1, PM2, PM3, PM9, and PM10) of Rhizobium isolates
The ability of Rhizobium strains to use 190 carbon sources and 95 nitrogen sources was tested using PM1 PM2, and PM3 (Biolog) (Fig. 3a,b and S3). The core of substrates, meaning substrates used by all the strains, was 51 for the carbon sources (4 amino acids of 27 tested, 44 carbohydrates of 93 tested, and 3 carboxylic acids of 47). The strains were diverse in their ability to use the remaining 40 carbon sources (9 amino acids, 15 carbohydrates, 13 carboxylic acids, 1 di-peptide, and 2 others). The remaining carbon sources (99) were not used by any of the strains. Strain 2ZE showed the lowest ability to use carbon sources [60 substrates (31.6% of the compounds tested)], while strains Z1 and 15ZE showed a higher ability to metabolize, respectively, 75 (39%) and 77 (40.5%) of the carbon sources tested. The strains showed a different capability to use the different classes of compounds (carbohydrates < amino acids < carboxylic acids). They used from 51.6 to 57.0% of the carbohydrates tested, from 22.2 to 44.4% of the amino acids tested, and from 8.5 to 25.5% of the carboxylic acid tested (Table 1).
For most of the carbohydrates used, we did not observe large differences among the strains. All the strains used carbon sources whose transporters are induced in R. leguminosarum sv. viciae 3841 during legume colonization: inositol transported by IntA; orbitol, mannitol, and dulcitol transported by MtlE; raffinose, melibiose, and lactose likely transported by a CUT1 (carbohydrate uptake transporter 1) family SBP (Ramachandran et al. 2011). All the strains were also able to use rhamnose, which has an important role in the early stages of the interaction of R. leguminosarum with clover plants (Oresnik et al. 1998). Furthermore, strains 2ZE, 9ZE, 13ZE, 14ZE, and 15ZE were able to use glycerol. It has been shown that the glp operon, harboring genes for the glycerol catabolism, was strongly induced by pea seed exudate and that mutants of R. leguminosarum sv. viciae VF39 unable to use glycerol showed lower nodulation capabilities (Ding et al. 2012). Strain Z1 showed a higher capability to metabolize different carbohydrates, and this was the only strain able to metabolize D-ribose, N-acetyl-D-mannosamine, N-acetyl-neuraminic acid, and N-acetyl-D-glucosaminitol. All strains (but strain 2ZE) were metabolically active on pectin. It has been demonstrated the presence of pectinolytic activity in rhizobia, but pectin supports lower levels of growth relative to other polysaccharides (Mateos et al. 1992; Knee et al. 2001); however, the lack of pectinolytic activity did not alter the nodulation process (Fauvart et al. 2009).
Dicarboxylic acids play the main role in bacteroid metabolism (Ronson and Primrose 1979; Duncan 1981). Plant photosynthate (sucrose) produced in the shoot is converted to dicarboxylates like succinate, fumarate, and malate (Day 1991) and is provided by the plant to the bacteroids as an energy source for N2 fixation (Poole and Allaway 2000; Lodwig and Poole 2003). Moreover, plants release large amounts of organic acids in the rhizosphere, contributing to shaping soil microbiota and soil acidification. Bacteria able to use the diverse organic acids secreted by plants then have an advantage in root colonization (Ramachandran et al. 2011). The PM analysis showed that strains 13ZE, 14ZE, 15ZE, and Z1 were able to use succinic and tartaric acid, which are both secreted by pea plants (Pini et al. 2017). Tartaric acid seems to be relevant for pea colonization, the expression of the MFS transporter of the tartrate gene (RL0996) of R. leguminosarum sv. viciae 3841 was upregulated in the pea rhizosphere and a mutation of this gene negatively affected pea colonization (Ramachandran et al. 2011). In the pea secretome, fumaric and malic acid are also present (Pini et al. 2017), but only two strains (15ZE and Z1) were able to use them (Fig. 3a), at least in free-living conditions.
Regarding the nitrogen source utilization, the core was represented by 40 compounds (10 amino acids, 2 inorganic compounds, 5 purines, 5 pyrimidines, 2 amino sugars, 11 dipeptides, and 5 others). There were 21 sources used only by some of the strains, and 34 compounds were not used by any strain. Strain Z1 and strain 15ZE showed the lowest and the highest ability to use nitrogen sources, metabolizing 45 (47.4% of the compounds tested) and 55 (57.9%) of the substrates tested respectively. Of the three inorganic compounds tested, all the strains were able to metabolize ammonium and nitrate, while nitrite was not used by any strain. All strains used the 12 di-peptides tested. They were also able to use quite a large number of amino sugars [from 3 (50.0%) to 5 (83.3%)], purine [from 5 (55.6%) to 6 (66.7%)], pyrimidines [4 (57.1%)] and amino acids [from 13 (39.4%) to 18 (54.5%)] (Table 1).
In terms of carbon and nitrogen utilization, strain Z1 formed an out-group with respect to all the other strains (Fig. S3A). The other strains could be subdivided into two groups: one included strains 13ZE and 15ZE and the other included strains 2ZE, 9ZE, and 14ZE, reflecting their different phylogenetic affiliations (Fig. 1 and S3A).
Rhizobium strains differ in their ability to use amino acids, and strain 15ZE was the strain with the highest ability to use these compounds both as carbon and nitrogen sources (Table 1). Out of six strains tested, only 15ZE, 14ZE, and 9ZE strains could use homoserine as a carbon source (Fig. 3a). Strains 13ZE and 15ZE had a similar pattern of amino acid utilization, and they were the only strains using L-ornithine and L-pyroglutamic acid. However, strain 13ZE was not able to metabolize L-homoserine as either a carbon or a nitrogen source. The amino acid homoserine is a major component of pea root exudate; it is released from the main root of pea seedlings during the formation of lateral roots (van Egeraat 1975). The utilization of homoserine is considered an important trait for rhizosphere colonization (Johnston et al. 1987; Hynes and O’Connell 1990) and the horizontal gene transfer of the homoserine gene cluster appears to contribute to rhizosphere colonization (Vanderlinde et al. 2014). Few differences were observed for amino sugars; in particular, strain Z1 showed a negative response for D-galactosamine and D-mannosamine but could use their acetylated forms. With respect to the other nitrogen compounds (peptides, purines, and pyrimidines), the pattern of utilization was similar among the strains tested except for xanthine (not used by strain Z1) and adenine (not used by strains 13ZE, 15ZE, and Z1).
The osmolyte sensitivity (PM9) characterization grouped the strains similar to the carbon and nitrogen utilization groups; Z1 formed an out-group, while the other strains were split into two groups with 13ZE and 15ZE separating from 2ZE, 4ZE, and 9ZE (Fig. S3B), also reflecting phylogenetic differences (Fig. 1).
All strains had low tolerance towards NaCl, showing only a very slight activity on the lowest concentration tested (1%). Rhizobia show marked variation in salt tolerance (Abdelmoumen et al. 1999) and tolerance to salinity of rhizobia was found to be correlated to the geographical location of the soil they inhabit (Cardoso et al. 2015). The low tolerance of the six Rhizobium strains to NaCl may reflect their adaptation to the native soil characterized by low salinity and rarely being subjected to desiccation. The tested osmoprotectors did not help the strains to counteract osmotic stress induced by 6% NaCl. Although trehalose is generally recognized as an osmoprotectant in R. leguminosarum (McIntyre et al. 2007), the strains were not active in the presence of trehalose and NaCl 6%. Nevertheless, it could not be excluded that trehalose may have a role in osmoprotection at lower NaCl concentrations. The strains did not show metabolic activity on potassium chloride (3–6%), sodium sulfate (2–5%), sodium formate (1–6%), urea (2–7%), sodium lactate (1–12%), or sodium benzoate (20–200 mM), while they tolerated 50 mM ammonium sulfate and 10 mM sodium nitrite. All the strains were resistant to the highest concentrations of ethylene glycol tested (20%). Strain Z1 showed higher tolerance to sodium phosphate and sodium nitrate relative to the other strains. Soil nitrate is one of the typical environmental stresses faced by the legume nodules and their symbiotic partner, inhibiting nodule formation and nitrogenase activity (Gibson and Harper 1985; Herridge and Brockwell 1988; Daimon 1999). However, Saxena et al. (1996) were able to isolate Rhizobium sp. strains that nodulated and maintain optimum levels of N fixation in the presence of 8 mM nitrate in combination with a common lentil cultivar host.
The metabolic activity of the Rhizobium strains over a broad range of pH (3.5–10) was evaluated. A relevant proportion of the world’s soils are acidic (pH < 5.5), and acidity is a widespread feature of Lithuanian soil (Ferguson et al. 2013). Rhizobial survival in soil and nodulation is highly influenced by soil pH (Graham et al. 1994). All the tested Rhizobium strains had high activity in the range of pH 6–8 (Fig. 3c). Strains 2ZE, 9ZE, and 14ZE tolerated pH 5.5 well, while strains 13ZE and 15ZE were more sensitive to acid pH and showed higher resistance to basic pH. Strain Z1 showed the highest range of pH resistance, being active in both acid and basic conditions. The obtained results agree with the reported low tolerance of Rhizobium to acid pH. Although certain strains of R. tropici and R. loti are highly acid-tolerant, in general rhizobia did not thrive at pH < 5 [67]. Similar to what was observed for our strains, strains of R. leguminosarum sv. viciae isolated in Lithuanian soils cannot tolerate acid pH lower than 5.5 (Lapinskas 2007). The ability of strain Z1 to tolerate pH 5.5 is likely one feature making this strain an effective symbiont in Lithuanian soil. Similarly, strains 2ZE, 9ZE, and 14ZE could be good inoculant candidates in this kind of soil.
The global analyses of PM data using a principal component analysis (PCA) divided the six strains into three groups; PC1 accounted for 51.9% of the variability, and PC2 accounted for 25.1%. Strain Z1 was alone in the two-dimensional space and was distinctly separated from strains 2ZE, 9ZE, 13ZE, 14ZE, and 15ZE on PC1. Along PC2, the separation of the other five strains into two main groups occurred; the first included 15ZE, 13ZE, and the second included 2ZE, 9ZE, and 14ZE (Fig. 3d). Observed phenotypic differences were mostly related to strain phylogenetic relationships. Strain Z1 (R. anhuiense) was characterized by a high ability to use many different carbon sources (in particular carboxylic acids, together with strain 15ZE), while it was the weakest in terms of nitrogen compound utilization. Moreover, it showed tolerance to a high range of pH. The R. leguminosarum strains of genospecies E (2ZE, 9ZE, and 14ZE) was shown to be well adapted to acidic pH (5.5), while strains of R. leguminosarum genospecies B (13ZE and 15ZE) were well adapted to basic pH. Strain 15ZE was more versatile in terms of carbon and nitrogen utilization.
3.3 Greenhouse experiment-assessment of nodulation efficiency and plant growth
The effectiveness of the six strains on Pisum sativum was evaluated by using two pea-breeding lines (‘DS 3637-2’ and ‘DS 3795-3’) that are new promising cultivars in Lithuania for their improved plant height, longer time of vegetation, and high yields (unpublished).
The two breeding lines showed different characters. The inoculated plants of the breeding line ‘DS 3637-2’ had shorter shoots, lower dry weights, and a higher number of nodules than the inoculated plants of the breeding line ‘DS 3795-3’, maintaining at the same time a similar number of nodes. The higher shoot length of ‘DS 3795-3’ should make this breeding line more advantaged in competition with weeds in respect to the shorter ‘DS 3637-2’ (McDonald 2003).
To value the effectiveness of the six strains in both the breeding lines, inoculated plants were compared with uninoculated plants. Plants inoculated with 9ZE, 14ZE, 15ZE, and Z1 strains had a significant increase in the shoot length compared to the uninoculated plants. Strain 2ZE only increased shoot length in the breeding line ‘DS 3795-3’ (Fig. 4a, Supplementary Table S1). Strains 14ZE and 15ZE were able to increase the number of nodes in the symbiotic interaction with ‘DS 3637-2’ and ‘DS 3795-3’, respectively, while strain Z1 increased the number of nodes in both pea-breeding lines (Fig. 4b, Supplementary Table S2). A significant increase of pea dry weight was only detected in breeding lines ‘DS 3795-3’ and ‘DS 3637-2’ inoculated with the strains 14ZE and Z1, respectively (Fig. 4c, Supplementary Table S1).
Plant parameters influenced by Rhizobium strains inoculation. a. Shoot length (cm), b. Number of nodes, c. Dry weight (g), d. φPo, the maximum quantum yield of primary photochemistry of a dark-adapted leaf e. Number of nodules of Pisum sativum plants inoculated or not with rhizobia strains. Light grey bars and dark grey bars indicate breeding lines ‘DS 3637–2’ and ‘DS 3795–3’, respectively. Average values calculated from five biological replicates are reported, with the standard error shown by error bars. Different letters (lower case letters for the breeding line ‘DS 3637–2’ and capital letters for ‘DS 3795–3’) indicate significant differences between strains (p ≤ 0.05, Tukey HSD and Dunn test post hoc test for normally distributed and nonnormal data respectively)
The maximum quantum yield of primary photochemistry in the dark-adapted state (φPo = Fv/Fm) is commonly employed as an index/proxy for photosynthetic efficiency (Baker and Rosenqvist 2004; Bussotti et al. 2011). The photosynthetic efficiencies of both breeding lines ‘DS 3795-3’ and ‘DS 3637-2’ were significantly enhanced by all strains (Fig. 4d, Supplementary Table S1). This finding was not consistent with the data reported by Zhou et al. (Zhou et al. 2006), who, when analyzing chlorophyll fluorescence parameters in soybean inoculated with Sinorhizobium fredii in the absence of nitrogen, found that rhizobial inoculation had no effects. However, chlorophyll a fluorescence activity, measured in field-grown chickpea plants having variable nodulation performance (high nodulating = HN; low nodulating = LN; non-nodulating = NN), was greater in nodulation variants (HN, and LN) than in the NN variants (Dudeja and Chaudhary 2005). Peng and coworkers (Peng et al. 2002) demonstrated that rhizobial strains were also able to increase single-leaf net photosynthetic rates in non-legumes, showing that the increase of photosynthetic rate could be not strictly linked to nitrogen fixation.
All strains induced the formation of nodules in both breeding lines; as expected, no nodules were detected in the negative controls (Fig. 4e). However, higher numbers of nodules were produced by all strains in the symbiotic interaction with breeding lines ‘DS 3637-2’ compared to breeding line ‘DS3795-3’ (Fig. 4e).
Overall, these results showed that strains Z1 and 14ZE were more effective at promoting the activity of P. sativum than the other strains tested, while 13ZE had the lowest effect on plant attributes. In both breeding lines, Z1 increased shoot length, the number of nodes, and φPo. Strain 14ZE positively affected shoot length as well as φPo in both breeding lines and it increased the dry weight and the number of nodes in ‘DS 3795-3’ and ‘DS 3637-2’, respectively. This result suggested that strain 14ZE may be an effective inoculant for Pisum sativum, similar to Z1, already known to efficiently stimulate the growth of Pisum sativum from practical field experience. Moreover, the effectiveness of 14ZE may be higher than Z1 and dependent on the inoculated breeding line.
A clear connection between the ability to stimulate P. sativum and nodC gene sequence cannot be found; strains 9ZE, 13ZE, and 15ZE, which shared similar nodC gene sequences (Fig. 1), were less effective than 14ZE and Z1. However, strain 2ZE, whose nodC sequence is phylogenetically closer to strain Z1 (Fig. 1), did not show effectiveness similar to that observed for Z1. Differences observed could then be linked to other rhizobial features. Indeed, several traits could be related to effectiveness: i) in the process of adhesion where rhizobia attach to root hairs using different mechanisms such as glucomannan at acidic pH, while at basic pH, the mechanism of adhesion is less understood, ii) variations in exopolysaccharide composition affect host specificity, iii) different strains may respond differently to nodule cysteine-rich peptides produced within the nodule to induce bacteroid differentiation, iv) differences could be related to nitrogenase activity, and v) rhizobia have complex pan-genome whose composition may affect strain effectiveness in different ways (Ghosh and Maiti 2016; Poole et al. 2018; Mendoza-Suárez et al. 2020). Phenotype microarray experiments showed that strain Z1 was able to use a higher number of carboxylic acids. Carboxylic acids are the fuel of bacteroids within nodules (in particular, L-malate, fumarate, and succinate), and this may explain the better effectiveness of strain Z1 and the lower effectiveness of strains 2ZE and 9ZE. Strain 15ZE showed a similar phenotype to strain Z1 for carboxylic acid utilization; in particular, this strain shared with strain Z1 the ability to use malic acid, which was not found in the other strains. Regardless, plants infected with strain 15ZE did not achieve a high yield as did strain Z1. However, the lack of utilization of malic acid or other carboxylic acids in free-living conditions is not conclusive regarding strain metabolic capabilities within nodules. Differences observed for other compounds have less impact on effectiveness; they may affect it indirectly decreasing/increasing rhizobia survivability in soil, which was not investigated in this study.
PCA was performed on the obtained data of plant performances for the two breeding lines subjected to the different inoculants. (Fig. 5). PC1 and PC2 together accounted for 93.12% and 85.35% of the variance in data obtained from breeding lines ‘DS 3637-2’ and ‘DS 3795-3’, respectively. There was a distinct separation between plants treated with bacteria and the uninoculated plants along with the PCs for both the breeding lines (Fig. 5a and b, respectively). A similar separation was observable without considering the number of nodules in the variables used (Fig. S4). Plants inoculated with the two most effective strains 14ZE and Z1 were separated from uninoculated plants along PC1 while a smaller separation was observed for plants inoculated with the other strains along with this PC. Plants inoculated with strain 13ZE, the less effective strain in stimulating pea, were the closest to uninoculated plants along PC1 for both breeding lines (Fig. 5).
PCA of attributes of plants inoculated with Rhizobium strains. Plants are indicated based on the inoculated strain. Shoot length (SL), number of nodes (ND), total plant dry weight (DW), photosynthetic yield (φPo), and nodule number (NDL)] were determined in A. Pisum sativum breeding line ‘DS 3637–2’ and b. Pisum sativum breeding line ‘DS 3795–3’ inoculated with Rhizobium isolates or not
The phenotypic analysis results did not match with in vitro plant test experiments, indicating that the phylogenetic and phenotypic differences observed are probably unlinked to symbiotic effectiveness. However, plant experiments were performed with single strains in sterile conditions using vermiculite and nitrogen-free media, which are the optimal conditions for nodulation. Thus, we cannot exclude that in natural conditions, with the presence of indigenous rhizobia, our strains may behave differently. Nevertheless, strain phenotypic differences should be taken into consideration in the translation from in vitro experiments to field experiments where soil features may play a major role in successful colonization. In soil, an increased metabolic versatility may confer competitive advantages; however, future studies on the competitive capabilities of these strains are required to infer a possible relation between strain phenotypic features and competitiveness.
4 Conclusions
The formulation of effective inoculants needs not only to take into account the symbiotic efficiency of the rhizobial strains used but also their phenotypic features expressed as adaptations to different soil conditions. Here, we used a multiphasic approach for the evaluation of the performance of strains by combining molecular characterization and phenotype microarray analysis with classic nodulation experiments. Phenotypic analyses were correlated to the different phylogenetic affiliations of strains, but they did not match with nodulation assays. Overall, the obtained results suggested that careful attention should be paid to inoculant selection because inoculant efficiency depends on the breeding line used. Rhizobium strains 14ZE (R. leguminosarum) and Z1 (R. anhuiense) could be employed as inoculants for the productivity amelioration of breeding lines ‘DS 3795-3’ and ‘DS 3637-2’, respectively.
References
Abdelmoumen H, Filali-Maltouf A, Neyra M, Belabed A, Missbah El Idrissi M (1999) Effect of high salts concentrations on the growth of rhizobia and responses to added osmotica. J Appl Microbiol 86:889–898. https://doi.org/10.1046/j.1365-2672.1999.00727.x
Abi-Ghanem R, Smith JL, Vandemark GJ (2013) Diversity of Rhizobium leguminosarum from pea fields in Washington state. ISRN Soil Sci 2013:786030–786037. https://doi.org/10.1155/2013/786030
Altschul SF, Gish W, Miller W, Myers EW, Lipman DJ (1990) Basic local alignment search tool. J Mol Biol 215:403–410. https://doi.org/10.1016/S0022-2836(05)80360-2
Andrews M, Andrews ME (2017) Specificity in legume-rhizobia symbioses. Int J Mol Sci 18:705. https://doi.org/10.3390/ijms18040705
Baker NR, Rosenqvist E (2004) Applications of chlorophyll fluorescence can improve crop production strategies: an examination of future possibilities. J Exp Bot 403:1607–1621. https://doi.org/10.1093/jxb/erh196
Baset Mia MA, Shamsuddin ZH (2010) Nitrogen fixation and transportation by rhizobacteria: a scenario of rice and banana. Int J Bot 6:235–242. https://doi.org/10.3923/ijb.2010.235.242
Bellabarba A, Fagorzi C, diCenzo GC, Pini F, Viti C, Checcucci A (2019) Deciphering the symbiotic plant microbiome: translating the most recent discoveries on rhizobia for the improvement of agricultural practices in metal-contaminated and high saline lands. Agronomy 9:529
Beringer JE (1974) R factor transfer in Rhizobium leguminosarum. J Gen Microbiol 84:188–198
Bhardwaj D, Ansari MW, Sahoo RK, Tuteja N (2014) Biofertilizers function as key player in sustainable agriculture by improving soil fertility, plant tolerance and crop productivity. Microb Cell Factories 13:66. https://doi.org/10.1186/1475-2859-13-66
Biondi EG, Tatti E, Comparini D, Giuntini E, Mocali S, Giovannetti L, Mengoni A, Bazzicalupo M, Viti C (2009) Metabolic capacity of Sinorhizobium (Ensifer) meliloti strains as determined by phenotype MicroArray analysis. Appl environ Microbiol 75:5396–5404. Doi: AEM.00196-09 [pii]https://doi.org/10.1128/AEM.00196-09
Bourion V, Heulin-Gotty K, Aubert V, Tisseyre P, Chabart-Martinello M, Pervent M, Delaitre C, Vile D, Siol M (2018) Co-inoculation of a pea core-collection with diverse rhizobial strains shows competitiveness for nodulation and efficiency of nitrogen fixation are distinct traits in the interaction. Front Plant Sci 8:2249. https://doi.org/10.3389/fpls.2017.02249
Bussotti F, Desotgiu R, Cascio C, Marzuoli R, Nali C, Lorenzini G, Salvatori E, Manes F, Schaub M, Strasser RJ (2011) Ozone stress in woody plants assessed with chlorophyll a fluorescence. A critical reassessment of existing data Environ Exp Bot doi 73:19–30. https://doi.org/10.1016/j.envexpbot.2010.10.022
Caccamo D, Di Cello F, Fani R, Gugliandolo C, Maugeri TL (1999) Polyphasic approach to the characterisation of marine luminous bacteria. Res Microbiol 150:221–230. https://doi.org/10.1016/S0923-2508(99)80039-4
Cardoso P, Freitas R, Figueira E (2015) Salt tolerance of rhizobial populations from contrasting environmental conditions: understanding the implications of climate change. Ecotoxicology 24:143–152. https://doi.org/10.1007/s10646-014-1366-8
Daimon H (1999) Nitrate-induced inhibition of root nodule formation and nitrogenase activity in the peanut (Arachis hypogaea L.). Plant Prod Sci 2:81–86. https://doi.org/10.1626/pps.2.81
Day D (1991) Carbon metabolism and compartmentation in nitrogen-fixing legume nodules. Plant Physiol Biochem 29:185–201
Denison RF, Kiers ET (2004) Lifestyle alternatives for rhizobia: mutualism, parasitism, and forgoing symbiosis. FEMS Microbiol Lett 237:187–193. https://doi.org/10.1016/j.femsle.2004.07.013
Ding H, Yip CB, Geddes BA, Oresnik IJ, Hynes MF (2012) Glycerol utilization by Rhizobium leguminosarum requires an ABC transporter and affects competition for nodulation. Microbiology 158:1369–1378. https://doi.org/10.1099/mic.0.057281-0
Drew EA, Denton MD, Sadras VO, Ballard RA (2012) Agronomic and environmental drivers of population size and symbiotic performance of Rhizobium leguminosarum bv. viciae in Mediterranean-type environments. Crop Pasture Sci 63:467–477. https://doi.org/10.1071/CP12032
Dudeja SS, Chaudhary P (2005) Fast chlorophyll fluorescence transient and nitrogen fixing ability of chickpea nodulation variants. Photosynthetica 43:253–259. https://doi.org/10.1007/s11099-005-0041-y
Duncan MJ (1981) Properties of Tn5-induced carbohydrate mutants in Rhizobium meliloti. J Gen Microbiol 122:61–67. https://doi.org/10.1099/00221287-122-1-61
Fagorzi C, Ilie A, Decorosi F, Cangioli L, Viti C, Mengoni A (2020) diCenzo GC (2020) symbiotic and non-symbiotic members of the genus Ensifer (syn. Sinorhizobium) are separated into two clades based on comparative genomics and high-throughput phenotyping. Genome Biol Evol. https://doi.org/10.1093/gbe/evaa221
FAOSTAT (2021) Food and agriculture Organization of the United Nations (FAO). FAOSTAT statistical database. In: http://www.fao.org/faostat/en/#data/QC. https://search.library.wisc.edu/catalog/999890171702121. Accessed 08/02/2021
Fauvart M, Verstraeten N, Dombrecht B, Venmans R, Beullens S, Heusdens C, Michiels J (2009) Rhizobium etli HrpW is a pectin-degrading enzyme and differs from phytopathogenic homologues in enzymically crucial tryptophan and glycine residues. Microbiology 155:3045–3054. https://doi.org/10.1099/mic.0.027599-0
Ferguson BJ, Lin MH, Gresshoff PM (2013) Regulation of legume nodulation by acidic growth conditions. Plant Signal Behav 8:e23426. https://doi.org/10.4161/psb.23426
Gage DJ (2004) Infection and invasion of roots by symbiotic, nitrogen-fixing rhizobia during nodulation of temperate legumes. Microbiol Mol Biol Rev 68:280–300. https://doi.org/10.1128/MMBR.68.2.280-300.200468/2/280
Gaunt MW, Turner SL, Rigottier-Gois L, Lloyd-Macgilp SA, Young JPW (2001) Phylogenies of atpD and recA support the small subunit rRNA-based classification of rhizobia. Int J Syst Evol Microbiol 51:2037–2048. https://doi.org/10.1099/00207713-51-6-2037
Gaworzewska ET, Carlile MJ (1982) Positive chemotaxis of Rhizobium leguminosarum and other bacteria towards root exudates from legumes and other plants. Microbiology 128:1179–1188. https://doi.org/10.1099/00221287-128-6-1179
Ghosh PK, Maiti TK (2016) Structure of extracellular polysaccharides (EPS) produced by rhizobia and their functions in legume–bacteria symbiosis: a review. Achiev Life Sci 10:136–143. https://doi.org/10.1016/j.als.2016.11.003
Gibson AH, Harper JE (1985) Nitrate effect on nodulation of soybean by Bradyrhizobium japonicum 1. Crop Sci 25:497–501. https://doi.org/10.2135/cropsci1985.0011183x002500030015x
Graham PH, Draeger KJ, Ferrey ML, Conroy MJ, Hammer BE, Martinez E, Aarons SR, Quinto C (1994) Acid pH tolerance in strains of Rhizobium and Bradyrhizobium, and initial studies on the basis for acid tolerance of Rhizobium tropici UMR1899. Can J Microbiol 40:198–297. https://doi.org/10.1139/m94-033
Hall TA (1999) BioEdit: A User-Friendly Biological Sequence Alignment Editor and Analysis Program for Windows 95/98/NT. Nucleic Acids Symposium Series 41:95–98
Hammer Ø, Harper DAT, Ryan PD (2001) PAST: paleontological statistics software packages for education and data analysis. Palaeontol Electron 4:XIX–XX
Herridge DF, Brockwell J (1988) Contributions of fixed nitrogen and soil nitrate to the nitrogen economy of irrigated soybean. Soil Biol Biochem 20:711–717. https://doi.org/10.1016/0038-0717(88)90156-3
Holt-Giménez E, Altieri MA (2013) Agroecology, food sovereignty, and the new green revolution. Agroecol Sustain Food Syst 37:90–102. https://doi.org/10.1080/10440046.2012.716388
Hynes MF, O’Connell MP (1990) Host plant effect on competition among strains of Rhizobium leguminosarum. Can J Microbiol 36:864–869. https://doi.org/10.1139/m90-150
Jaeger CH, Lindow SE, Miller W, Clark E, Firestone MK (1999) Mapping of sugar and amino acid availability in soil around roots with bacterial sensors of sucrose and tryptophan. Appl Environ Microbiol 65:2685–2690. https://doi.org/10.1128/aem.65.6.2685-2690.1999
Johnston AWB, Downie JA, Rossen L, Shearman CA, Firmin JL, Borthakur D, Wood EA, Bradley D, Brewin NJ, Vincent JM, Haselkorn R, Jones DG, Minchin FR, Dobereiner J, Sprent JI (1987) Molecular analysis of the Rhizobium genes involved in the induction of nitrogen-fixing nodules on legumes. Philos Trans R Soc Lond Ser B Biol Sci 317:193–207
Jorrin B, Palacios JM, Peix Á, Imperial J (2020) Rhizobium ruizarguesonis sp. nov., isolated from nodules of Pisum sativum L. Syst Appl Microbiol 43:126090. https://doi.org/10.1016/j.syapm.2020.126090
Knee EM, Gong FC, Gao M, Teplitski M, Jones AR, Foxworthy A, Mort AJ, Bauer WD (2001) Root mucilage from pea and its utilization by rhizosphere bacteria as a sole carbon source. Mol Plant-Microbe Interact 6:775–784. https://doi.org/10.1094/MPMI.2001.14.6.775
Kumar PP, Antony LVM, Kumar M (2009) Phylogenetic diversity of cultivable bacteria associated with filamentous non-hetrocystous marine cyanobacteria. Biology
Kumar N, Lad G, Giuntini E, Kaye ME, Udomwong P, Jannah Shamsani N, Young JPW, Bailly X (2015) Bacterial genospecies that are not ecologically coherent: population genomics of Rhizobium leguminosarum. Open Biol 5:140133. https://doi.org/10.1098/rsob.140133
Kumar S, Stecher G, Li M, Knyaz C, Tamura K (2018) MEGA X: molecular evolutionary genetics analysis across computing platforms. Mol Biol Evol 35:1547–1549. https://doi.org/10.1093/molbev/msy096
Laguerre G, Nour SM, Macheret V, Sanjuan J, Drouin P, Amarger N (2001) Classification of rhizobia based on nodC and nifH gene analysis reveals a close phylogenetic relationship among Phaseolus vulgaris symbionts. Microbiology 147:981–993. https://doi.org/10.1099/00221287-147-4-981
Lane DJ (1991) 16S/23S rRNA Sequencing. Nucleic acid Tech Bact Syst 160:781–791. https://doi.org/10.1007/s00227-012-2133-0
Lapinskas EB (2007) The effect of acidity on the distribution and symbiotic efficiency of rhizobia in Lithuanian soils. Eurasian Soil Sci 40:419–425. https://doi.org/10.1134/S1064229307040084
Lodwig EM, Poole PS (2003) Metabolism of Rhizobium bacteroids. CRC Crit Rev Plant Sci 22:37–78
Mateos PF, Jimenez-Zurdo JI, Chen J, Squartini AS, Haack SK, Martinez-Molina E, Hubbell DH, Dazzo FB (1992) Cell-associated pectinolytic and cellulolytic enzymes in Rhizobium leguminosarum biovar trifolii. Appl Environ Microbiol 58:1816–1822. https://doi.org/10.1128/aem.58.6.1816-1822.1992
McDonald GK (2003) Competitiveness against grass weeds in field pea genotypes. Weed Res 43:48–58. https://doi.org/10.1046/j.1365-3180.2003.00316.x
McIntyre HJ, Davies H, Hore TA, Miller SH, Dufour JP, Ronson CW (2007) Trehalose biosynthesis in Rhizobium leguminosarum by. trifolii and its role in desiccation tolerance. Appl Environ Microbiol 73:3984–3992. https://doi.org/10.1128/AEM.00412-07
Mendoza-Suárez MA, Geddes BA, Sánchez-Cañizares C, Ramírez-González RH, Kirchhelle C, Jorrin B, Poole PS (2020) Optimizing Rhizobium-legume symbioses by simultaneous measurement of rhizobial competitiveness and N2 fixation in nodules. Proc Natl Acad Sci 117:9822–9831. https://doi.org/10.1073/pnas.1921225117
Mutch LA, Young JPW (2004) Diversity and specificity of Rhizobium leguminosarum biovar viciae on wild and cultivated legumes. Mol Ecol 13:2435–2444. https://doi.org/10.1111/j.1365-294X.2004.02259.x
Oresnik IJ, Pacarynuk LA, O’Brien SAP, Yost CK, Hynes MF (1998) Plasmid-encoded catabolic genes in rhizobium leguminosarum bv. Trifolii: evidence for a plant-inducible rhamnose locus involved in competition for nodulation. Mol Plant-Microbe Interact 12:1175–1185. https://doi.org/10.1094/MPMI.1998.11.12.1175
Pastor-Bueis R, Sánchez-Cañizares C, James EK, González-Andrés F (2019) Formulation of a highly effective inoculant for common bean based on an autochthonous elite strain of Rhizobium leguminosarum bv. phaseoli, and genomic-based insights into its agronomic performance. Front Microbiol 10:2724. https://doi.org/10.3389/fmicb.2019.02724
Peix A, Ramírez-Bahena MH, Velázquez E, Bedmar EJ (2015) Bacterial associations with legumes. CRC Crit Rev Plant Sci 34:17–42. https://doi.org/10.1080/07352689.2014.897899
Peng S, Biswas JC, Ladha JK, Gyaneshwar P, Chen Y (2002) Influence of rhizobial inoculation on photosynthesis and grain yield of rice. Agron J 4:925–029. https://doi.org/10.2134/agronj2002.9250
Pini F, East AK, Appia-Ayme C, Tomek J, Karunakaran R, Mendoza-Suarez M, Edwards A, Terpolilli JJ, Roworth J, Downie JA, Poole PS (2017) Bacterial biosensors for in vivo spatiotemporal mapping of root secretion. Plant Physiol 174:1289–1306. https://doi.org/10.1104/pp.16.01302
Poole P, Allaway D (2020) Carbon and nitrogen metabolism in Rhizobium. Adv Microb Physiol 43:117–63. doi: 10.1016/s0065-2911(00)43004-3. PMID: 10907556
Poole PS, Ramachandran V, Terpolilli J (2018) Rhizobia: from saprophytes to endosymbionts. Nat Rev Microbiol 16:291–303. https://doi.org/10.1038/nrmicro.2017.171
R Core Team (2018) R: A language and environment for statistical computing. R Foundation for Statistical Computing, Vienna, Austria. URL https://www.R-project.org/
Rahi P, Giram P, Chaudhari D, DiCenzo GC, Kiran S, Khullar A, Chandel M, Gawari S, Mohan A, Chavan S, Mahajan B (2020) Rhizobium indicum sp. nov., isolated from root nodules of pea (Pisum sativum) cultivated in the Indian trans-Himalayas. Syst Appl Microbiol 43:126127. https://doi.org/10.1016/j.syapm.2020.126127
Ramachandran VK, East AK, Karunakaran R, Downie JA, Poole PS (2011) Adaptation of Rhizobium leguminosarum to pea, alfalfa and sugar beet rhizospheres investigated by comparative transcriptomics. Genome Biol 12:R106. https://doi.org/10.1186/gb-2011-12-10-r106
Rogel MA, Ormeño-Orrillo E, Martinez Romero E (2011) Symbiovars in rhizobia reflect bacterial adaptation to legumes. Syst Appl Microbiol 34:96–104. https://doi.org/10.1016/j.syapm.2010.11.015
Ronson CW, Primrose SB (1979) Carbohydrate metabolism in Rhizobium trifolii: identification and symbiotic properties of mutants. J Gen Microbiol 112:77–88. https://doi.org/10.1099/00221287-112-1-77
Ruisi P, Giambalvo D, Di Miceli G, Frenda AS, Saia S, Amato G (2012) Tillage effects on yield and nitrogen fixation of legumes in mediterranean conditions. Agron J 104:1459–1466. https://doi.org/10.2134/agronj2012.0070
Saeed AI, Sharov V, White J, Li J, Liang W, Bhagabati N, Braisted J, Klapa M, Currier T, Thiagarajan M, Sturn A, Snuffin M, Rezantsev A, Popov D, Ryltsov A, Kostukovich E, Borisovsky I, Liu Z, Vinsavich A, Trush V, Quackenbush J (2003) TM4: a free, open-source system for microarray data management and analysis. Biotechniques 34:374–378. https://doi.org/10.2144/03342mt01
Saitou N, Nei M (1987) The neighbor-joining method: a new method for reconstructing phylogenetic trees. Mol Biol Evol 4:406–425
Saxena AK, Rathi SK, Tilak KVBR (1996) Selection and evaluation of nitrate-tolerant strains of Rhizobium leguminosarum biovar viceae specific to the lentil. Biol Fertil Soils 22:126–130. https://doi.org/10.1007/BF00384443
Seibutis V, Deveikyté I (2006) Pea yield and its components in different crop rotations. Zemdirbyste-Agriculture 93:263–270
Smil V (2004) Enriching the earth: Fritz Haber, Carl Bosch, and the transformation of world food production. MIT Press, Cambridge
Sneath PHA, Sokal RR (1962) Numerical taxonomy. Nature. 193:855–860. https://doi.org/10.1038/193855a0
Stecher G, Tamura K, Kumar S (2020) Molecular evolutionary genetics analysis (MEGA) for macOS. Mol Biol Evol 37:1237–1239. https://doi.org/10.1093/molbev/msz312
Tamura K, Nei M, Kumar S (2004) Prospects for inferring very large phylogenies by using the neighbor-joining method. Proc Natl Acad Sci U S A 101:11030–11035. https://doi.org/10.1073/pnas.0404206101
Udvardi M, Poole PS (2013) Transport and metabolism in legume-rhizobia symbioses. Annu Rev Plant Biol 64:781–805. https://doi.org/10.1146/annurev-arplant-050312-120235
van Egeraat AWSM (1975) The possible role of homoserine in the development of Rhizobium leguminosarum in the rhizosphere of pea seedlings. Plant Soil 42:381–386. https://doi.org/10.1007/BF00010013
Vanderlinde EM, Hynes MF, Yost CK (2014) Homoserine catabolism by Rhizobium leguminosarum bv. viciae 3841 requires a plasmid-borne gene cluster that also affects competitiveness for nodulation. Environ Microbiol 16:205–217. https://doi.org/10.1111/1462-2920.12196
Vincent JM (1970) A manual for the practical study of root-nodule bacteria, . I.B.P. Handbook. Blackwell Sci Publ, Oxford
Wielbo J, Marek-Kozaczuk M, Kubik-Komar A, Skorupska A (2007) Increased metabolic potential of Rhizobium spp. is associated with bacterial competitiveness. Can J Microbiol 53:957–967. https://doi.org/10.1139/W07-053
Wielbo J, Marek-Kozaczuk M, Mazur A, Kubik-Komar A, Skorupska A (2010) Genetic and metabolic divergence within a Rhizobium leguminosarum bv. trifolii population recovered from clover nodules. Appl Environ Microbiol 76:4593–4600. https://doi.org/10.1128/AEM.00667-10
Young JPW, Moeskjær S, Afonin A, Rahi P, Maluk M, James EK, Cavassim MIA, Rashid MH-o, Aserse AA, Perry BJ, Wang ET, Velázquez E, Andronov EE, Tampakaki A, Flores Félix JD, Rivas González R, Youseif SH, Lepetit M, Boivin S, Jorrin B, Kenicer GJ, Peix Á, Hynes MF, Ramírez-Bahena MH, Gulati A, Tian C-F (2021) Defining the Rhizobium leguminosarum species complex. Genes 12: 111 https://doi.org/10.3390/genes12010111
Zhang F, Smith DL (2002) Interorganismal signaling in suboptimum environments: the legume-rhizobia symbiosis. Adv Agron 76:125–161. https://doi.org/10.1016/s0065-2113(02)76004-5
Zhang J, Shang Y, Peng S, Chen W, Wang E, de Lajudie P, Li B, Guo C, Liu C (2019) Rhizobium sophorae, Rhizobium laguerreae, and two novel Rhizobium genospecies associated with Vicia sativa L. in Northwest China. Plant Soil 442:113–126. https://doi.org/10.1007/s11104-019-04168-w
Zhou XJ, Liang Y, Chen H, Shen SH, Jing YX (2006) Effects of rhizobia inoculation and nitrogen fertilization on photosynthetic physiology of soybean. Photosynthetica 44:530–535. https://doi.org/10.1007/s11099-006-0066-x
Acknowledgments
This study has received funding from the Research Council of Lithuania (LMTLT) through the high-level R&D project “Enhancement of the multifunctional properties of legumes in feed and food value chains (SmartLegume), grant number––01.2.2-LMT-K-718-01-0068.
Author information
Authors and Affiliations
Corresponding author
Additional information
Publisher’s note
Springer Nature remains neutral with regard to jurisdictional claims in published maps and institutional affiliations.
Supplementary Information
Rights and permissions
About this article
Cite this article
Suproniene, S., Decorosi, F., Pini, F. et al. Selection of Rhizobium strains for inoculation of Lithuanian Pisum sativum breeding lines. Symbiosis 83, 193–208 (2021). https://doi.org/10.1007/s13199-021-00747-7
Received:
Accepted:
Published:
Issue Date:
DOI: https://doi.org/10.1007/s13199-021-00747-7